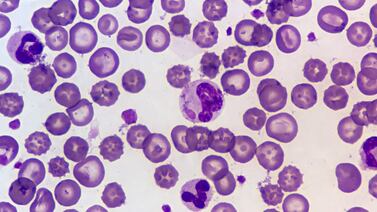
¿Qué es distemper? La mortal enfermedad que, aparentemente, se propaga entre los perros ticos

El distemer felino es casi tan mortal como el distemper para perros
Etiquetas distemper
El distemper ha encendido las señaeñaes de alerta entre los veterinarios del país
El distemper, en la mayoría de casos, es una enfermedad mortal para las mascotas